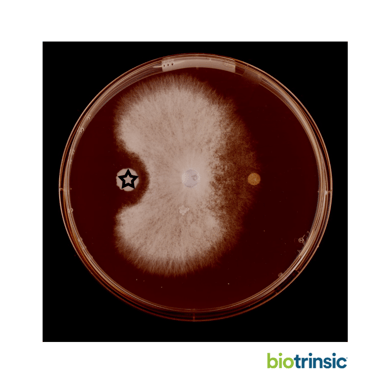
BIO-Blog_dish_1080

What's the Big Deal About Microbes?
In the past 20 years, research on the human microbiome has revealed that there are many microorganisms in and on the human body. That research is now being paralleled in agriculture to better understand what's known as the plant microbiome. Many of these microorganisms, which live on the inside or near the surface of plants, have co-evolved with the plant and are important to their health and development.
At Indigo, we've developed biotrinsic®, an innovative collection of biological seed treatments that harness the power of the plant microbiome to make plants more resilient to environmental stressors such as heat, moisture, pests and disease. In this post, we’ll share highlights of our process for discovering microbes and how we are turning them into powerful crop-enhancing seed treatments for farmers.
But First: What are Microbes Doing in Plants Anyway?
Microbial ecologists have known for a long time that there are microorganisms that have evolved to combat or mitigate a variety of environmental stresses - both biotic stresses such as fungal diseases or insect attacks, and abiotic stresses like nutrient deficiency and drought stress.
For example, beneficial fungi often produce antibiotic molecules that inhibit the growth of pathogenic strains. In the image below, a fungal strain (around the edge of the Petri dish) is inhibiting the growth of the Rhizoctonia pathogen (in the center).
Some bacteria produce plant hormones that can improve plant growth, alter plant physiology, or affect biochemical processes to help plants withstand both biotic and abiotic stresses. In this second example, a plant colonized by a Phyllobacterium produces a plant auxin. The bacterium causes a dramatic increase in lateral root formation compared to the untreated on the left hand side which may help the plant take up water or nutrients from the soil.
Some bacteria produce plant hormones that can improve plant growth, alter plant physiology, or affect biochemical processes to help plants withstand both biotic and abiotic stresses. In this second example, a plant colonized by a Phyllobacterium produces a plant auxin. The bacterium causes a dramatic increase in lateral root formation compared to the untreated on the left hand side which may help the plant take up water or nutrients from the soil.
At Indigo, we seek to discover and understand what microorganisms are present in healthy plants - of different varieties, in different regions, and in different environmental stress and field conditions - and then reintroduce those microbes to seeds as a sort of plant probiotic that will help crops withstand harsh conditions. Our product research has primarily focused on a subset of microorganisms known as endophytes, which make their homes inside plant tissues and in close association with the root rhizosphere, forming a close long-term association with their plant host.
A single gram of plant tissue contains a rich microbial community with thousands of unique strains of bacteria and fungi, so how do Indigo scientists discover helpful microbes and turn them into effective seed treatments? It is a complex process that requires a lot of time, expertise, and rigorous testing.
- Finding Microbes in the Field - Indigo researchers travel to agricultural fields experiencing stresses of interest and find a plant that seems more resilient to that stress than its neighbors. They collect those healthy plants and their non-healthy counterparts and sequence the microbial community present in these two subpopulations. Is the microbiome of the healthy plant providing an advantage? Sometimes we find out that it is, and this kicks off a process of closer examination to understand it further and add it to our library of microbes.
- Building a Library of Microbes - When Indigo researchers discover an endophyte that is helping plants withstand environmental stressors, they add it to Indigo's strain library, which is one of the most diverse libraries of endophytes in the world. Indigo has collected over 8,000 plant tissue samples, each of which host hundreds of thousands of microbes, from across the US from various crops and various environmental conditions. For each of those tissue samples, Indigo scientists have recorded detailed sequences for all of the microorganisms that reside in the tissue samples, giving us a deep understanding of plant microbiome communities. Indigo’s library houses more than 25,000 crop-associated microbes isolated and identified to date. More than 4,000 of those are distinct genera and hundreds of those are novel species, meaning that they are newly discovered and now being identified. Among our collection there are filamentous fungi, yeast, bacteria, and algae.
- Nominating Microbial Strains for Product Development - We use the data from our library to predict or nominate which strains might be best candidates for testing in our R&D pipeline to build new biologicals.
- Testing Products in the Field - The ones that are identified in Indigo's sourcing program become the focus of rigorous lab, greenhouse, and eventually, field testing. When it comes to field testing, Indigo scientists start with small trials but eventually, successful seed treatments are tested on a commercial scale so that they can be manufactured and distributed commercially.
- The Final biotrinsic® Product - Our products take one of three forms: liquid seed treatment, wettable powder, or flowable powder. Indigo’s biotrinsic® products are designed to be compatible with a combination of plant treatments that address the specific issues unique to a farmer’s field.
Curious about how our scientists develop microbes into seed treatments at a commercial scale? Visit our post, “A Microbe’s Journey from Lab to Field.”


